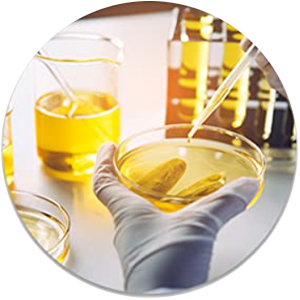
SPN-LO4C5 B0746352SP Sankalp Grams iodine solution 100ml

SANKALP LABS Grams Iodine Solution -100ML
- 12 Months cover from date of purchase for New Smart Phones
- Repair of device for Accidental and/or Liquid damage.
- Max 2 repair requests, cumulatively capped upto the device invoice value.
- Like to Like replacement
- Free Pick-up & Drop
- 14 Working Days TAT
Ever accidentally spilt coffee, tea or water on your phone? Did your phone ever get drenched in the rain? All of these can damage parts within your phone and make it unusable or non-responsive just when you most need it. Smartphones are fragile and prone to physical damage. So we recommend you buy this accidental damage and liquid protection cover. Fixing a liquid damaged Smartphone is expensive and time consuming if it isn't covered under the manufacturer warranty or extended warranty. Buying this Extended Warranty for your smartphone will protect your phone for 12 months.
| Validity | 1 Year |
|---|---|
| Brand | Reliance Retails |
| Warranty | 1 Year on handset. 6 months on accessories |
Items are eligible for return within 7 Days of Delivery*. All accessories, product & packaging need to beEver accidentally spilt coffee, tea or water on your phone? Did your phone ever get drenched in the rain? All of these can damage parts within your phone and make it unusable or non-responsive just when you most need it. Smartphones are fragile and prone to physical damage. So we recommend you buy this accidental damage and liquid protection cover. Fixing a liquid damaged Smartphone is expensive and time consuming if it isn't covered under the manufacturer warranty or extended warranty. Buying this Extended Warranty for your smartphone will protect your phone for 12 months.
Samsung 138 cm smart television with Pureview QLED
1 Year resQ Care Plan. Accidental and liquid damage Protection for LCD
Amount Payable:
- Used for starch testing.
- Perfect for use in any biology lab
- Laboratory-grade material for lab & research use